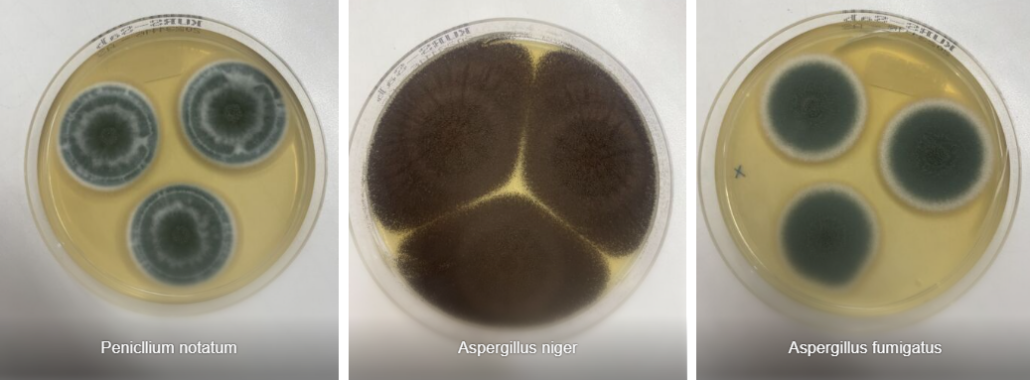
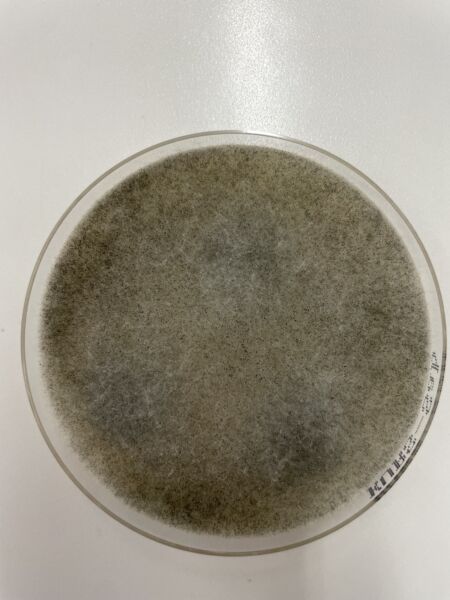
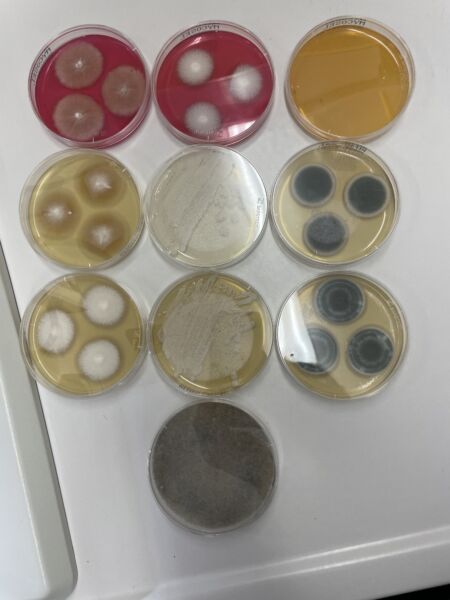

Mycotoxins are toxic substances produced by molds that can develop in the environment, during transport, or in food storage, and they can cause poisoning. This illness is known as mycotoxicosis.
Some molds can act against bacteria or other pathogens and inhibit their growth; therefore, certain species are used in the production of antibiotics (such as penicillin or cephalosporins).

Mold in hay can make rabbits sick.
Contents
What do molds and toxins contain?
Food, substrates, and similar materials should come from a reliable source and be stored dry to prevent the growth of molds.
- Hay
- Straw
- Dried herbs
- Dry food
- Vegetables
- Fruits
- Seeds, cereals…
- Bedding material
- Indoor spaces or enclosed areas
- Damp wood, for example due to contact with the ground
Mold in hay?
Hay should always be carefully checked before being given to animals. Ideally, the producer should send a sample to a laboratory. However, an inspection using all the senses is usually enough to detect mold.
Signs of mold in hay:
- Hay is damp
- Presence of white areas
- Musty or moldy smell
- Dark or black spots
In addition, other hazards can be hidden in hay (for example, toxic plants); here you can find information on how to recognize them: hay

How are molds detected? Diagnosis
Molds often go largely unnoticed and are not only ingested through food, but also inhaled through the air. Even small amounts can cause illness.

Often, at the beginning, only some animals become ill; certain rabbits seem to be more sensitive than others. Mycotoxins exploit weaknesses in the immune system, which is why molds and their toxins often go unnoticed for quite a long time. In the long term, animals become more susceptible to disease and repeatedly show the symptoms described below.
If there is suspicion, feed samples can be sent to a laboratory. A veterinarian can provide guidance and, in some cases, perform an initial microscopic examination. A pathological examination can also provide useful information; in this case, the suspicion should be indicated on the submission form so that appropriate tests are carried out.

• Microscopy of direct preparations: fresh with Blankophor, lactophenol cotton blue, as well as special stains for histology
• Culture on media specific for fungi (e.g., Sabouraud): slightly acidic pH (5.6), 2–4% glucose (D) or maltose (HS), with bacterial inhibitors such as cycloheximide and chloramphenicol
• Biochemical differentiation
• Molecular identification: genetic detection (PCR) or mass spectrometry (MALDI-TOF)
• Toxin analysis: mass spectrometry (ELISA)
Agar plates with mold cultures for the identification of fungi in rabbits (Penicillium notatum).

How to recognize diseases caused by mycotoxins: symptoms

Depending on the mycotoxin involved, symptoms can vary considerably. However, all of the following signs may be associated with the presence of molds:
General condition and behavior:
• apathetic or withdrawn behavior, reduced feed intake, poor weight gain, little response to the environment, low body weight; in some cases, death within 24–48 hours without other symptoms or after prior signs; impaired motor coordination (unsteadiness, staggering), fever is rare, increased susceptibility to infections, weakened immune system, increased thirst and urination
Nervous system:
• seizures, hyperexcitability, ataxia, coma, intracranial hypertension syndrome (pressing the head against objects, circling movements), facial paralysis (deviation of the muzzle), paralysis, spasms, involuntary movements or tremors
Upper digestive tract:
• inflammation, edema, swelling, and necrosis of the lips and oral mucosa, laryngeal paralysis, difficulty swallowing, ulcers and inflammation in the oral cavity, salivation, inflammation of the gastric mucosa and small intestine
Lower digestive tract:
• bloating (gas accumulation), diarrhea (sometimes bloody), rectal prolapse, enteritis, intestinal infections
Upper respiratory tract:
• breathing difficulties or dyspnea, nosebleeds, rapid breathing, respiratory paralysis, nasal discharge, mouth breathing, cyanotic mucous membranes
Cardiovascular system:
• cardiac and circulatory weakness, tachycardia
Musculoskeletal system:
• cold extremities, joint stiffness, lameness
Eyes and eyelids:
• conjunctivitis, visual disturbances up to blindness
Urinary tract:
• increased urination, increased water intake, kidney damage
Skin, coat, and mucous membranes:
• skin inflammation in the mouth and head region, yellowish mucous membranes (jaundice), subcutaneous hemorrhages, edema due to fluid accumulation in tissues (e.g., as a result of liver damage), wounds, ulcers, and necrosis of the skin and mucous membranes, mainly on the head but also on other parts of the body, lesions on the mammary glands
Blood and hematopoiesis:
• coagulation disorders and weakened immune system due to thrombocytopenia and leukopenia, anemia, hemorrhages
Fertility, offspring, and lactation:
• possible abortions, reduced milk production, feminization of males, inflammation of the vaginal mucosa, swelling of the vulva, enlargement of mammary glands and nipples, reduced or absent milk production, hyperestrogenism, reduced fertility, weakness during birth, mortality of offspring, malformations (genetic damage)
Main representatives of mycotoxin-producing molds:
• Aspergillus spp.: aflatoxins, ochratoxins
• Claviceps spp.: ergot alkaloids
• Fusarium spp.: trichothecenes, zearalenone, fumonisins
• Monascus spp.: citrinin
• Penicillium spp.: ochratoxins, citrinin, patulin
• Stachybotrys spp.: satratoxins
Hier ist die Tabelle sauber auf Englisch strukturiert:
| Mold toxin and mold species | Occurrence | (Toxic) effects | Symptoms |
|---|---|---|---|
| Aflatoxins (Aspergillus spp.) | Cereals, maize, contaminated environments (skin contact, inhalation) | Hepatotoxic, carcinogenic, acute toxicity; aflatoxin B1 = most potent mycotoxic carcinogen | Diarrhea, bloody or black feces, respiratory distress, pale or yellowish mucous membranes, anemia, abdominal fluid accumulation (ascites), coagulation disorders, weakened immune system, poor feed intake, weight loss, impaired coordination, circling, sudden death, teeth grinding, twitching of the ears or other body parts, tremors, salivation, foaming at the mouth, severe diarrhea, rectal prolapse, dry and inflamed conjunctiva, blindness, skin inflammation, subcutaneous hemorrhages (hematomas), bleeding, anemia, reduced milk production, abortions, impaired blood clotting, weakened immune system |
| Alternariol (AOH), AME (Alternaria spp.) | Fruits, vegetables, millet, nuts | Mutagenic | Anorexia, ataxia, apathy, recumbency, coma, intracranial pressure syndrome (pressing the head against objects, circling behavior), anorexia, weight loss; depression, recumbency, death; in the pulmonary form initially restlessness, rapidly worsening tachypnea and terminal dyspnea with open-mouth breathing, seizures, tremors, hyperexcitability; in the hepatic form jaundice, in the pulmonary form terminal cyanosis (bluish mucous membranes). Pharyngeal paralysis, swallowing disorders, visual disturbances up to blindness, jaundice, edema (as a result of liver damage), sweating, and occasionally coagulation disorders (due to liver damage). |
| Citrinin (Aspergillus ochraceus, Penicillium citrinum) | Cereals | Hepatotoxic, nephrotoxic, carcinogenic | |
| Deoxynivalenol (DON) (Fusarium culmorum, F. graminearum) | Maize, wheat, barley, oats | Gastrointestinal irritant | |
| Fumonisins (Fusarium spp.) | Maize, cereals | Possibly carcinogenic, teratogenic | |
| Kojic acid (Aspergillus, Penicillium) | Maize | Weakly mutagenic, moderately antibiotic, epilepsy-like symptoms in animal studies | |
| Moniliformin (Fusarium spp.) | Maize, barley | Gastroenteric, hemorrhagic | |
| Nivalenol (Fusarium culmorum) | Maize, barley, wheat | Hemorrhagic | |
| Ochratoxin A (OTA) (Aspergillus ochraceus, Penicillium viridicatum) | Maize, wheat | Nephrotoxic, dermatotoxic, carcinogenic | |
| Patulin (Penicillium spp.) | Apples | Hemorrhagic, edematous, carcinogenic (animal studies) | |
| Satratoxins (Stachybotrys chartarum, S. atra) | Hay, especially straw, dried herbs, water-damaged environments | Systemic toxicity | Anorexia, depression, rarely fever, stomatitis, necrosis of the oral mucosa, salivation. With prolonged exposure: colic, gastroenteritis, diarrhea, dyspnea, nosebleeds, cardiac and circulatory weakness, conjunctivitis, inflammation of the skin in the head region, edema (“hippopotamus head”), skin exudates with thick crusts on the lips and nostrils, petechial hemorrhages, coagulation disorders and immunosuppression due to thrombocytopenia and leukopenia. Abortions may occur, death, restlessness, mucosal necrosis, nosebleeds. |
| Sterigmatocystin (Aspergillus) | Barley, maize, wheat, rice | Carcinogenic, hepatotoxic, nephrotoxic | |
| Tenuazonic acid (Alternaria alternata) | Apples, tomatoes | Antiviral, low toxicity, inhibits protein synthesis | |
| Trichothecenes (mainly Fusarium, also Stachybotrys, etc.) | Cereals, contaminated environments (skin/inhalation) | Diverse toxic effects | Anorexia, possible facial paralysis, lip edema, ulcerative stomatitis, salivation, stomatitis, necrosis of the oral mucosa, salivation. With prolonged exposure: colic, diarrhea (sometimes bloody), dyspnea, nosebleeds, cardiac and circulatory weakness, conjunctivitis, inflammation of the skin in the head region, coagulation disorders and immunosuppression due to thrombocytopenia and leukopenia, possible abortions, reduced milk production. Gastroenteritis, diarrhea, dyspnea, visual disturbances up to blindness, coagulation disorders with hemorrhages. |
| Verruculogen (Penicillium verrucosum, Aspergillus fumigatus) | Cereals | Tremorgenic, possibly tumor-promoting | |
| Zearalenone (ZEA) (Fusarium spp.) | Cereals, maize, nuts, silage, contaminated environments | Estrogenic effect, infertility |
What can be done? Treatment
Immediately remove the rabbits from the contaminated environment and house them elsewhere.

Antifungal agents (topical and systemic) do not treat the symptoms, but they can eliminate the molds. They must be administered over a prolonged period.
In addition, symptomatic treatment should be applied; for example, digestive medications in cases of bloating, and fluid therapy in cases of organ damage, etc.
Warning: Mold toxins are also harmful to humans. Therefore, contact should be avoided.
Environmental disinfection
Hydrogen peroxide: very effective and breaks down into water and oxygen (safe for humans and animals)
Bleach (sodium hypochlorite): very effective, but harmful to health. Use only on completely washable surfaces; do not apply to wood, as it may damage it.
Precautionary measures
• Use protective gloves
• Do not touch mold without gloves
• Wear a mask (at least FFP2, preferably FFP3); avoid inhaling large amounts of mold spores
• Use well-fitting protective goggles
• Thoroughly wash or dispose of everything afterward, including clothing
Testimonial – half of the rabbits die due to mold in the hay
“We went through an absolute nightmare! Suddenly, rabbits started developing inflammation of the lips and tongue, and no cause could be found. The teeth appeared normal or showed only minor points that could not explain such severe inflammation. That everything was just a coincidence, as the veterinarians suggested, became less and less believable after repeated deaths…
For years, I had never had dental problems in my rabbits, and suddenly they were supposed to occur all at once by chance? After long investigations, examinations, and laboratory diagnostics, we finally found an explanation: with the hay, I had brought poison into the enclosure.
A few weeks earlier, for once I hadn’t bought hay from my usual supplier, but instead got a few bales from a nearby farmer. The quality didn’t convince me: it wasn’t as green, didn’t smell as fresh, and was somewhat dusty. “Well, we’ll use it up and then I’ll buy better hay again,” I thought… I had no idea that this decision would be fatal and would cost almost half the group their lives.
When Nougat fell ill, dental problems were suspected. A few weeks later, Müsli developed tongue inflammation and died shortly after a dental correction. We thought it was kidney failure due to anesthesia. Mochi died a few weeks later in my arms. And so, one after another, the rabbits fell ill, and none responded to antibiotics or other treatments.
They didn’t always show the same symptoms, so at first it wasn’t obvious that there was a connection. However, all of them died within a few days of diagnosis, regardless of the treatment used.
The first signs are often lesions in the oral mucosa, swelling of the tongue, and eye inflammation, although nasal discharge, respiratory issues, and digestive problems may also occur.
The ingested toxins impair the formation of white blood cells, weakening the immune system and promoting secondary diseases.
Once symptoms appear, treatment is unfortunately difficult. In our case, even after performing an antibiogram, no antibiotic or alternative treatment worked. The prognosis was poor, and after the first symptoms appeared, all affected animals died within a short time.

Additionally, the intervals between cases were relatively long, sometimes several weeks. Two rabbits never became ill at the same time, which made it even harder to recognize the connection.
After a long investigation and costly laboratory analyses, the cause was finally identified: the hay was contaminated with a black mold whose mycotoxins caused the inflammation in the oral cavity. A necropsy and laboratory analysis of a deceased rabbit showed that internal organs such as the lungs, liver, kidneys, and spleen were inflamed, leading to acute organ failure. The mycotoxins produced by the mold had been slowly poisoning the animals. Moreover, by storing new hay in the same container, it became recontaminated with already present spores.
The observed symptoms were typical of diseases caused by the black mold Stachybotrys. However, this pathogen is still rarely considered today by veterinarians and animal caretakers, even though it is repeatedly detected in laboratory analyses. Diseases caused by mycotoxins are often nonspecific and difficult to identify, so the causes are frequently not recognized or detected too late. Possible symptoms include bloating, diarrhea, respiratory problems, rhinitis, eye inflammation, neurological disorders, and especially inflammation and necrosis of mucous membranes and internal organs.
Once the cause was identified, I was able to take action: I cleaned everything thoroughly several times and sprayed it with 11% hydrogen peroxide, discarded some materials, replaced others, and disinfected the entire rabbit housing — including cages, hutches, and furniture — with an ozone generator. Ozone eliminates bacteria, viruses, molds, and parasites and also reaches all corners, not just surfaces like sprays. I hope I have finally eliminated the cause and that this nightmare is over.
From my perspective, the remaining animals are doing much better since then. They seem more comfortable indoors and eat hay better. I hope these are good signs.
I have deliberately written this text in an objective way. You know how much I love my animals, but right now I cannot share this story from an emotional perspective. There have been too many losses, and it hurts too much. I hope this information helps other caretakers consider molds as a possible cause of illness and take action in time.”






















